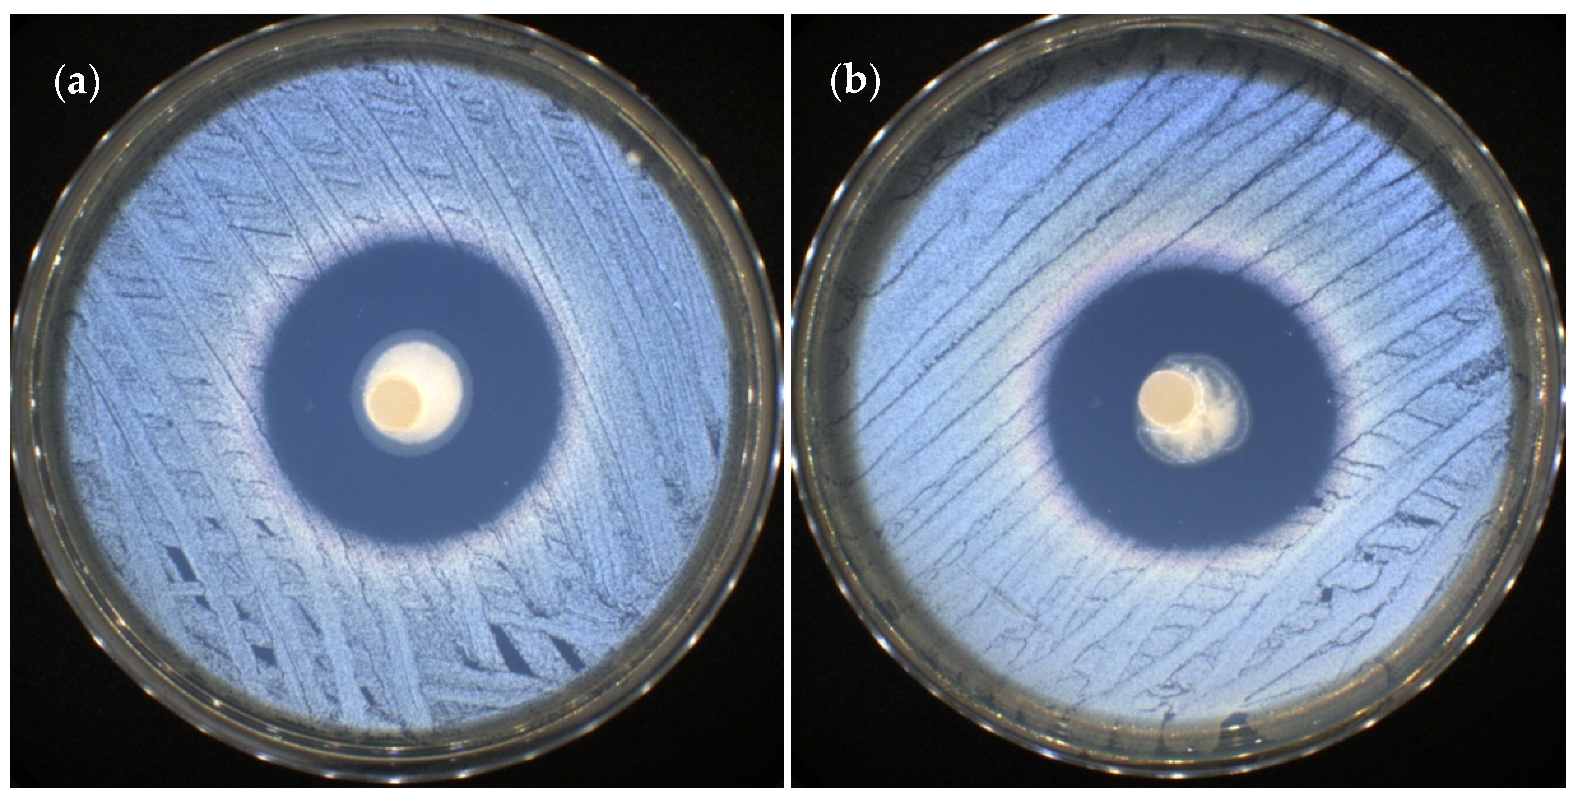
Pharmaceutics 15 00975 g012 Pharmaceutics 15 00975 g012

New Smart Bioactive and Biomimetic Chitosan-Based Hydrogels for Wounds Care Management
Abstract
1. Introduction
2. Materials and Methods
2.1. Materials
2.2. Methods
2.2.1. Preparation of CS-oxCS/oxHA and API-CS-oxCS/oxHA Hydrogels
2.2.2. Physicochemical Characterization of CS-oxCS/oxHA and API-CS-oxCS/oxHA Hydrogels
Macroscopic Aspect and Microscopic Analysis
Fourier-Transform Infrared Spectroscopy (FT-IR)
Scanning Electron Microscopy (SEM)
Swelling Degree Test
Determination of pH
Rheological Behavior
Amplitude Sweep Test
Thixotropic Test
2.2.3. Biological Evaluation Using In Vitro Assays
Cell Viability Assay
Antimicrobial Assay
3. Results and Discussions
3.1. Physicochemical Characterization of CS-oxCS/oxHA and API-CS-oxCS/oxHA Hydrogels
3.1.1. Macroscopic and Microscopic Features
3.1.2. Scanning Electron Microscopy (SEM)
3.1.3. FT-IR Spectroscopy
3.1.4. Swelling Degree
3.1.5. pH Value
3.1.6. Rheological Behavior
Amplitude Sweep Test
Thixotropic Test
3.2. Biological Evaluation Using In Vitro Assays
3.2.1. Cell Viability Assay
3.2.2. Antimicrobial Assay
4. Conclusions
Supplementary Materials
Author Contributions
Funding
Institutional Review Board Statement
Data Availability Statement
Conflicts of Interest
References
- Yao, Z.; Niu, J.; Cheng, B. Prevalence of Chronic Skin Wounds and Their Risk Factors in an Inpatient Hospital Setting in Northern China. Adv. Ski. Wound Care 2020, 33, 1–10. [Google Scholar] [CrossRef] [PubMed]
- Järbrink, K.; Ni, G.; Sönnergren, H.; Schmidtchen, A.; Pang, C.; Bajpai, R.; Car, J. Prevalence and Incidence of Chronic Wounds and Related Complications: A Protocol for a Systematic Review. Syst. Rev. 2016, 5, 152. [Google Scholar] [CrossRef]
- Sen, C.K. Human Wounds and Its Burden: An Updated Compendium of Estimates. Adv. Wound Care 2019, 8, 39–48. [Google Scholar] [CrossRef] [PubMed]
- Las Heras, K.; Igartua, M.; Santos-Vizcaino, E.; Hernandez, R.M. Chronic Wounds: Current Status, Available Strategies and Emerging Therapeutic Solutions. J. Control. Release 2020, 328, 532–550. [Google Scholar] [CrossRef] [PubMed]
- Olsson, M.; Järbrink, K.; Divakar, U.; Bajpai, R.; Upton, Z.; Schmidtchen, A.; Car, J. The Humanistic and Economic Burden of Chronic Wounds: A Systematic Review. Wound Repair Regen. 2019, 27, 114–125. [Google Scholar] [CrossRef]
- Voljč, T.; Semenič, D. Contribution of Topical Agents to Wound Healing. In Recent Advances in Wound Healing; Aghaei, S., Ed.; IntechOpen: London, UK, 2022; ISBN 978-1-83968-572-9. [Google Scholar]
- Powers, J.G.; Higham, C.; Broussard, K.; Phillips, T.J. Wound Healing and Treating Wounds: Chronic Wound Care and Management. J. Am. Acad. Dermatol. 2016, 74, 607–625. [Google Scholar] [CrossRef]
- Bowers, S.; Franco, E. Chronic Wounds: Evaluation and Management. Am. Fam. Physician 2020, 101, 159–166. [Google Scholar]
- Wound-Management-Guidelines. Available online: https://www.bcpft.nhs.uk/documents/policies/w/1444-wound-management-guidelines/file (accessed on 17 January 2023).
- Jones, R.E.; Foster, D.S.; Longaker, M.T. Management of Chronic Wounds-2018. JAMA 2018, 320, 1481–1482. [Google Scholar] [CrossRef]
- Doughty, D. Dressings and More: Guidelines for Topical Wound Management. Nurs. Clin. N. Am. 2005, 40, 217–231. [Google Scholar] [CrossRef]
- Öhnstedt, E.; Lofton Tomenius, H.; Vågesjö, E.; Phillipson, M. The Discovery and Development of Topical Medicines for Wound Healing. Expert Opin. Drug Discov. 2019, 14, 485–497. [Google Scholar] [CrossRef]
- Moore, Z.E.; Webster, J. Dressings and Topical Agents for Preventing Pressure Ulcers. Cochrane Database Syst. Rev. 2018, 12, CD009362. [Google Scholar] [CrossRef] [PubMed]
- Derwin, R.; Patton, D.; Avsar, P.; Strapp, H.; Moore, Z. The Impact of Topical Agents and Dressing on pH and Temperature on Wound Healing: A Systematic, Narrative Review. Int. Wound J. 2022, 19, 1397–1408. [Google Scholar] [CrossRef] [PubMed]
- Cheng, S.; Wang, H.; Pan, X.; Zhang, C.; Zhang, K.; Chen, Z.; Dong, W.; Xie, A.; Qi, X. Dendritic Hydrogels with Robust Inherent Antibacterial Properties for Promoting Bacteria-Infected Wound Healing. ACS Appl. Mater. Interfaces 2022, 14, 11144–11155. [Google Scholar] [CrossRef]
- Sethuram, L.; Thomas, J. Therapeutic Applications of Electrospun Nanofibers Impregnated with Various Biological Macromolecules for Effective Wound Healing Strategy—A Review. Biomed. Pharmacother. 2023, 157, 113996. [Google Scholar] [CrossRef]
- Moholkar, D.N.; Sadalage, P.S.; Peixoto, D.; Paiva-Santos, A.C.; Pawar, K.D. Recent Advances in Biopolymer-Based Formulations for Wound Healing Applications. Eur. Polym. J. 2021, 160, 110784. [Google Scholar] [CrossRef]
- Mo, C.; Xiang, L.; Chen, Y. Advances in Injectable and Self-Healing Polysaccharide Hydrogel Based on the Schiff Base Reaction. Macromol. Rapid Commun. 2021, 42, e2100025. [Google Scholar] [CrossRef]
- Xiang, J.; Shen, L.; Hong, Y. Status and Future Scope of Hydrogels in Wound Healing: Synthesis, Materials and Evaluation. Eur. Polym. J. 2020, 130, 109609. [Google Scholar] [CrossRef]
- Bahram, M.; Mohseni, N.; Moghtader, M. An Introduction to Hydrogels and Some Recent Applications. In Emerging Concepts in Analysis and Applications of Hydrogels; IntechOpen: London, UK, 2016. [Google Scholar]
- Caló, E.; Khutoryanskiy, V.V. Biomedical Applications of Hydrogels: A Review of Patents and Commercial Products. Eur. Polym. J. 2015, 65, 252–267. [Google Scholar] [CrossRef]
- Brumberg, V.; Astrelina, T.; Malivanova, T.; Samoilov, A. Modern Wound Dressings: Hydrogel Dressings. Biomedicines 2021, 9, 1235. [Google Scholar] [CrossRef]
- Ghasemiyeh, P.; Mohammadi-Samani, S. Hydrogels as Drug Delivery Systems; Pros and Cons. Trends Pharm. Sci. 2019, 5, 7–24. [Google Scholar]
- Bordbar-Khiabani, A.; Gasik, M. Smart Hydrogels for Advanced Drug Delivery Systems. Int. J. Mol. Sci. 2022, 23, 3665. [Google Scholar] [CrossRef] [PubMed]
- Farahani, M.; Shafiee, A. Wound Healing: From Passive to Smart Dressings. Adv. Healthc. Mater. 2021, 10, e2100477. [Google Scholar] [CrossRef]
- Berger, J.; Reist, M.; Mayer, J.M.; Felt, O.; Peppas, N.A.; Gurny, R. Structure and Interactions in Covalently and Ionically Crosslinked Chitosan Hydrogels for Biomedical Applications. Eur. J. Pharm. Biopharm. 2004, 57, 19–34. [Google Scholar] [CrossRef]
- Han, Y.; Cao, Y.; Lei, H. Dynamic Covalent Hydrogels: Strong yet Dynamic. Gels 2022, 8, 577. [Google Scholar] [CrossRef]
- Li, Y.; Wang, X.; Fu, Y.; Wei, Y.; Zhao, L.; Tao, L. Self-Adapting Hydrogel to Improve the Therapeutic Effect in Wound-Healing. ACS Appl. Mater. Interfaces 2018, 10, 26046–26055. [Google Scholar] [CrossRef]
- Talebian, S.; Mehrali, M.; Taebnia, N.; Pennisi, C.P.; Kadumudi, F.B.; Foroughi, J.; Hasany, M.; Nikkhah, M.; Akbari, M.; Orive, G.; et al. Self-Healing Hydrogels: The Next Paradigm Shift in Tissue Engineering? Adv. Sci. 2019, 6, 1801664. [Google Scholar] [CrossRef]
- Barroso, N.; Guaresti, O.; Pérez-Álvarez, L.; Ruiz-Rubio, L.; Gabilondo, N.; Vilas-Vilela, J.L. Self-Healable Hyaluronic Acid/Chitosan Polyelectrolyte Complex Hydrogels and Multilayers. Eur. Polym. J. 2019, 120, 109268. [Google Scholar] [CrossRef]
- Samal, S.K.; Dash, M.; Dubruel, P.; Van Vlierberghe, S. Smart Polymer Hydrogels: Properties, Synthesis and Applications. In Smart Polymers and Their Applications; Elsevier: Amsterdam, The Netherlands, 2014; pp. 237–270. [Google Scholar]
- Tian, S.; Wang, M.; Wang, X.; Wang, L.; Yang, D.; Nie, J.; Ma, G. Smart Hydrogel Sensors with Antifreezing, Antifouling Properties for Wound Healing. ACS Biomater. Sci. Eng. 2022, 8, 1867–1877. [Google Scholar] [CrossRef]
- Crini, G. Historical Review on Chitin and Chitosan Biopolymers. Environ. Chem. Lett. 2019, 17, 1623–1643. [Google Scholar] [CrossRef]
- Kulkarni, N.; Shinde, S.D.; Jadhav, G.S.; Adsare, D.R.; Rao, K.; Kachhia, M.; Maingle, M.; Patil, S.P.; Arya, N.; Sahu, B. Peptide-Chitosan Engineered Scaffolds for Biomedical Applications. Bioconjugate Chem. 2021, 32, 448–465. [Google Scholar] [CrossRef]
- Seidi, F.; Khodadadi Yazdi, M.; Jouyandeh, M.; Dominic, M.; Naeim, H.; Nezhad, M.N.; Bagheri, B.; Habibzadeh, S.; Zarrintaj, P.; Saeb, M.R.; et al. Chitosan-Based Blends for Biomedical Applications. Int. J. Biol. Macromol. 2021, 183, 1818–1850. [Google Scholar] [CrossRef]
- Patrulea, V.; Ostafe, V.; Borchard, G.; Jordan, O. Chitosan as a Starting Material for Wound Healing Applications. Eur. J. Pharm. Biopharm. 2015, 97, 417–426. [Google Scholar] [CrossRef] [PubMed]
- Azad, A.K.; Sermsintham, N.; Chandrkrachang, S.; Stevens, W.F. Chitosan Membrane as a Wound-Healing Dressing: Characterization and Clinical Application. J. Biomed. Mater. Res. B Appl. Biomater. 2004, 69, 216–222. [Google Scholar] [CrossRef]
- Dai, T.; Tanaka, M.; Huang, Y.-Y.; Hamblin, M.R. Chitosan Preparations for Wounds and Burns: Antimicrobial and Wound-Healing Effects. Expert Rev. Anti Infect. Ther. 2011, 9, 857–879. [Google Scholar] [CrossRef] [PubMed]
- Minagawa, T.; Okamura, Y.; Shigemasa, Y.; Minami, S.; Okamoto, Y. Effects of Molecular Weight and Deacetylation Degree of Chitin/Chitosan on Wound Healing. Carbohydr. Polym. 2007, 4, 640–644. [Google Scholar] [CrossRef]
- Cao, R.; Yu, H.; Long, H.; Zhang, H.; Hao, C.; Shi, L.; Du, Y.; Jiao, S.; Guo, A.; Ma, L.; et al. Low Deacetylation Degree Chitosan Oligosaccharide Protects against IL-1β Induced Inflammation and Enhances Autophagy Activity in Human Chondrocytes. J. Biomater. Sci. Polym. Ed. 2022, 33, 517–531. [Google Scholar] [CrossRef]
- Jin, Y.; Ling, P.-X.; He, Y.-L.; Zhang, T.-M. Effects of Chitosan and Heparin on Early Extension of Burns. Burns 2007, 33, 1027–1031. [Google Scholar] [CrossRef] [PubMed]
- Alsarra, I.A. Chitosan Topical Gel Formulation in the Management of Burn Wounds. Int. J. Biol. Macromol. 2009, 45, 16–21. [Google Scholar] [CrossRef]
- Ong, S.-Y.; Wu, J.; Moochhala, S.M.; Tan, M.-H.; Lu, J. Development of a Chitosan-Based Wound Dressing with Improved Hemostatic and Antimicrobial Properties. Biomaterials 2008, 29, 4323–4332. [Google Scholar] [CrossRef] [PubMed]
- Satitsri, S.; Muanprasat, C. Chitin and Chitosan Derivatives as Biomaterial Resources for Biological and Biomedical Applications. Molecules 2020, 25, 5961. [Google Scholar] [CrossRef]
- Ardean, C.; Davidescu, C.M.; Nemeş, N.S.; Negrea, A.; Ciopec, M.; Duteanu, N.; Negrea, P.; Duda-Seiman, D.; Musta, V. Factors Influencing the Antibacterial Activity of Chitosan and Chitosan Modified by Functionalization. Int. J. Mol. Sci. 2021, 22, 7449. [Google Scholar] [CrossRef]
- Amirian, J.; Zeng, Y.; Shekh, M.I.; Sharma, G.; Stadler, F.J.; Song, J.; Du, B.; Zhu, Y. In-Situ Crosslinked Hydrogel Based on Amidated Pectin/Oxidized Chitosan as Potential Wound Dressing for Skin Repairing. Carbohydr. Polym. 2021, 251, 117005. [Google Scholar] [CrossRef] [PubMed]
- Bao, Z.; Yu, A.; Shi, H.; Hu, Y.; Jin, B.; Lin, D.; Dai, M.; Lei, L.; Li, X.; Wang, Y. Glycol Chitosan/Oxidized Hyaluronic Acid Hydrogel Film for Topical Ocular Delivery of Dexamethasone and Levofloxacin. Int. J. Biol. Macromol. 2021, 167, 659–666. [Google Scholar] [CrossRef] [PubMed]
- Kuth, S.; Karakaya, E.; Reiter, N.; Schmidt, L.; Paulsen, F.; Teßmar, J.; Budday, S.; Boccaccini, A.R. Oxidized Hyaluronic Acid-Gelatin-Based Hydrogels for Tissue Engineering and Soft Tissue Mimicking. Tissue Eng. Part C Methods 2022, 28, 301–313. [Google Scholar] [CrossRef]
- Ma, L.; Tan, Y.; Chen, X.; Ran, Y.; Tong, Q.; Tang, L.; Su, W.; Wang, X.; Li, X. Injectable Oxidized Alginate/Carboxylmethyl Chitosan Hydrogels Functionalized with Nanoparticles for Wound Repair. Carbohydr. Polym. 2022, 293, 119733. [Google Scholar] [CrossRef] [PubMed]
- Weng, L.; Chen, X.; Chen, W. Rheological Characterization of in Situ Crosslinkable Hydrogels Formulated from Oxidized Dextran and N-Carboxyethyl Chitosan. Biomacromolecules 2007, 8, 1109–1115. [Google Scholar] [CrossRef]
- Qi, X.; Xiang, Y.; Cai, E.; You, S.; Gao, T.; Lan, Y.; Deng, H.; Li, Z.; Hu, R.; Shen, J. All-in-one: Harnessing Multifunctional Injectable Natural Hydrogels for Ordered Therapy of Bacteria-Infected Diabetic Wounds. Chem. Eng. J. 2022, 439, 135691. [Google Scholar] [CrossRef]
- Wang, Y.; Xie, R.; Li, Q.; Dai, F.; Lan, G.; Shang, S.; Lu, F. A Self-Adapting Hydrogel Based on Chitosan/Oxidized Konjac Glucomannan/AgNPs for Repairing Irregular Wounds. Biomater. Sci. 2020, 8, 1910–1922. [Google Scholar] [CrossRef]
- Yang, H.; Song, L.; Zou, Y.; Sun, D.; Wang, L.; Yu, Z.; Guo, J. Role of Hyaluronic Acids and Potential as Regenerative Biomaterials in Wound Healing. ACS Appl. Bio Mater. 2021, 4, 311–324. [Google Scholar] [CrossRef]
- Fallacara, A.; Baldini, E.; Manfredini, S.; Vertuani, S. Hyaluronic Acid in the third Millennium. Polymers 2018, 10, 701. [Google Scholar] [CrossRef]
- Ke, C.; Sun, L.; Qiao, D.; Wang, D.; Zeng, X. Antioxidant Acitivity of low Molecular Weight Hyaluronic Acid. Food Chem. Toxicol. 2011, 49, 2670–2675. [Google Scholar] [CrossRef]
- de Paiva, W.K.V.; de Medeiros, W.R.D.B.; de Assis, C.F.; Dos Santos, E.S.; de Sousa Júnior, F.C. Physicochemical Characterization and in Vitro Antioxidant Activity of Hyaluronic Acid Produced by Streptococcus Zooepidemicus CCT 7546. Prep. Biochem. Biotechnol. 2022, 52, 234–243. [Google Scholar] [CrossRef] [PubMed]
- Nyman, E.; Henricson, J.; Ghafouri, B.; Anderson, C.D.; Kratz, G. Hyaluronic Acid Accelerates Re-Epithelialization and Alters Protein Expression in a Human Wound Model. Plast. Reconstr. Surg. Glob. Open 2019, 7, e2221. [Google Scholar] [CrossRef] [PubMed]
- Litwiniuk, M.; Krejner, A.; Speyrer, M.S.; Gauto, A.R.; Grzela, T. Hyaluronic Acid in Inflammation and Tissue Regeneration. Wounds 2016, 28, 78–88. [Google Scholar]
- Sen, S.O.; Nayak, A.K.; Devbhuti, P.; Ghosh, A. Modification of Gums by Periodate Oxidation: A Natural Cross-Linker. Int. J. Pharm. Pharm. Sci. 2019, 11, 1–6. [Google Scholar] [CrossRef]
- Koosha, M.; Aalipour, H.; Sarraf Shirazi, M.J.; Jebali, A.; Chi, H.; Hamedi, S.; Wang, N.; Li, T.; Moravvej, H. Physically Crosslinked Chitosan/PVA Hydrogels Containing Honey and Allantoin with Long-Term Biocompatibility for Skin Wound Repair: An In Vitro and In Vivo Study. J. Funct. Biomater. 2021, 12, 61. [Google Scholar] [CrossRef]
- Sharma, M.; Malik, G.; Gulati, D.; Kaushik, P.; Arora, S. Formulation and evaluation of fusidic acid based transferosome for burn wound infection. Mater. Today Proc. 2022, 68, 836–841. [Google Scholar] [CrossRef]
- Lemaire, S.; Van Bambeke, F.; Pierard, D.; Appelbaum, P.C.; Tulkens, P.M. Activity of Fusidic Acid Against Extracellular and Intracellular Staphylococcus Aureus: Influence of PH and Comparison With Linezolid and Clindamycin. Clin. Infect. Dis. 2011, 52, S493–S503. [Google Scholar] [CrossRef]
- Fernandes, P. Fusidic Acid: A Bacterial Elongation Factor Inhibitor for the Oral Treatment of Acute and Chronic Staphylococcal Infections. Cold Spring Harb. Perspect. Med. 2016, 6, a025437. [Google Scholar] [CrossRef]
- Nokoorani, Y.D.; Shamloo, A.; Bahadoran, M.; Moravvej, H. Fabrication and Characterization of Scaffolds Containing Different Amounts of Allantoin for Skin Tissue Engineering. Sci. Rep. 2021, 11, 16164. [Google Scholar] [CrossRef]
- Dinica, R.M.; Sandu, C.; Dediu Botezatu, A.V.; Cazanevscaia Busuioc, A.; Balanescu, F.; Ionica Mihaila, M.D.; Dumitru, C.N.; Furdui, B.; Iancu, A.V. Allantoin from Valuable Romanian Animal and Plant Sources with Promising Anti-Inflammatory Activity as a Nutricosmetic Ingredient. Sustainability 2021, 13, 10170. [Google Scholar] [CrossRef]
- Becker, L.C.; Bergfeld, W.F.; Belsito, D.V.; Klaassen, C.D.; Marks, J.G.; Shank, R.C.; Slaga, T.J.; Snyder, P.W.; Andersen, F.A. Final Report of the Safety Assessment of Allantoin and Its Related Complexes. Int. J. Toxicol. 2010, 29, 84S–97S. [Google Scholar] [CrossRef] [PubMed]
- Liu, Q.; Sun, Y.; Cui, Q.; Cheng, J.; Killpartrik, A.; Kemp, A.H.; Guo, M. Characterization, antioxidant capacity, and bioaccessibility of Coenzyme Q10 loaded whey protein nanoparticles. LWT 2022, 160, 113258. [Google Scholar] [CrossRef]
- Temova Rakuša, Ž.; Kristl, A.; Roškar, R. Stability of Reduced and Oxidized Coenzyme Q10 in Finished Products. Antioxidants 2021, 10, 360. [Google Scholar] [CrossRef] [PubMed]
- Fir, M.M.; Smidovnik, A.; Milivojevic, L.; Zmitek, J.; Prosek, M. Studies of CoQ10 and Cyclodextrin Complexes: Solubility, Thermo- and Photo-Stability. J. Incl. Phenom. Macrocycl. Chem. 2009, 64, 225–232. [Google Scholar] [CrossRef]
- Suri, A.; Pratt, A.; Tear, S.; Walker, C.; El-Gomati, M. Next Generation Secondary Electron Detector with Energy Analysis Capability for SEM. J. Microsc. 2020, 279, 207–211. [Google Scholar] [CrossRef] [PubMed]
- Rheology: Basics of Rheometry-Oscillation: Anton Paar Wiki. Available online: https://wiki.anton-paar.com/en/basics-of-rheometry-oscillation/ (accessed on 19 January 2023).
- Yilmaz, M.T.; Vatansever, C. Three Interval Thixotropy Test to Determine Structural Regeneration of a Glucomannan Based Hydrocolloid Film at Air/Water Interface: Interfacial, Molecular, Thermal and Surface Characterization. Food Hydrocoll. 2016, 61, 458–468. [Google Scholar] [CrossRef]
- ISO 10993-5: 2009 (E); Biological Evaluation of Medical Devices—Part 5: Tests for In Vitro Cytotoxicity. ISO: Geneva, Switzerland, 2009.
- Bauer, A.W.; Perry, D.M.; Kirby, W.M. Single disc antibiotic sensitivity testing of Staphylococci. AMA Arch. Intern. Med. 1959, 104, 208–216. [Google Scholar] [CrossRef]
- Clinical and Laboratory Standards Institute (CLSI). Performance Standards for Antimicrobial Susceptibility Testing, 32nd ed.; CLSI Supplement M100; Clinical and Laboratory Standards Institute (CLSI): San Antonio, TX, USA, 2022; ISBN 978-1-68440-134-5/978-1-68440-135-2. [Google Scholar]
- XLSTAT|Statistical Software for Excel, n.d. Available online: https://www.xlstat.com/en (accessed on 9 February 2023).
- Metzler, C.M.; Cahill, A.; Metzler, D.E. Equilibriums and Absorption Spectra of Schiff Bases. J. Am. Chem. Soc. 1980, 102, 6075–6082. [Google Scholar] [CrossRef]
- Mauricio-Sánchez, R.A.; Salazar, R.; Luna-Bárcenas, G.L.; Mendoza-Galván, A. FTIR Spectroscopy Studies on the Spontaneous Neutralization of Chitosan Acetate Films by Moisture Conditioning. Vib. Spectrosc. 2018, 9, 1–6. [Google Scholar]
- Riaz, U.; Ashraf, S.M. Chapter 20. Characterization of Polymer Blends with FTIR Spectroscopy. In Characterization of Polymer Blends with FTIR Spectroscopy; Thomas, S., Grohens, Y., Jyotishkumar, P., Eds.; Wiley Online Library: Weinheim, Germany, 2014. [Google Scholar]
- Op’t Veld, R.C.; Walboomers, X.F.; Jansen, J.A.; Wagener, F.A.D.T.G. Design Considerations for Hydrogel Wound Dressings: Strategic and Molecular Advances. Tissue Eng. Part B Rev. 2020, 26, 230–248. [Google Scholar] [CrossRef] [PubMed]
- Nuutila, K.; Eriksson, E. Moist Wound Healing with Commonly Available Dressings. Adv. Wound Care 2021, 10, 685–698. [Google Scholar] [CrossRef]
- Cui, L.; Yao, Y.; Yim, E.K.F. The Effects of Surface Topography Modification on Hydrogel Properties. APL Bioeng. 2021, 5, 031509. [Google Scholar] [CrossRef] [PubMed]
- Junker, J.P.E.; Kamel, R.A.; Caterson, E.J.; Eriksson, E. Clinical Impact Upon Wound Healing and Inflammation in Moist, Wet, and Dry Environments. Adv. Wound Care 2013, 2, 348–356. [Google Scholar] [CrossRef] [PubMed]
- Proksch, E. PH in Nature, Humans and Skin. J. Dermatol. 2018, 45, 1044–1052. [Google Scholar] [CrossRef]
- Rippke, F.; Berardesca, E.; Weber, T.M. PH and Microbial Infections. Curr. Probl. Dermatol. 2018, 54, 87–94. [Google Scholar]
- Wang, Y.; Li, X.; Zhao, W.; Gao, Z.Z.; Zheng, M.J.; Pang, Y.L.; Chen, Z.Y. Advances in the Research of Influence of pH Value on Healing of Chronic Wounds. Zhonghua Shao Shang Za Zhi 2019, 35, 474–476. [Google Scholar]
- Wallace, L.A.; Gwynne, L.; Jenkins, T. Challenges and Opportunities of pH in Chronic Wounds. Ther. Deliv. 2019, 10, 719–735. [Google Scholar] [CrossRef]
- Rheology: Basics of Rheometry-Rotation: Anton Paar Wiki. Available online: https://wiki.anton-paar.com/en/basics-of-rheometry-rotation/ (accessed on 19 January 2023).
- Mezger, T. Applied Rheology: With Joe Flow on Rheology Road, 8th ed.; Anton Paar GmbH: Graz, Austria, 2021; ISBN 978-3-9504016-0-8. [Google Scholar]
- Jons, C.K.; Grosskopf, A.K.; Yan, J.; Klich, J.H.; Saouaf, O.M.; Appel, E.A. Yield-Stress and Creep Control Depot Formation and Persistence of Injectable Hydrogels Following Subcutaneous Administration. Adv. Funct. Mater. 2022, 32, 40–42. [Google Scholar] [CrossRef]
- Amplitude Sweeps: Anton Paar Wiki. Available online: https://wiki.anton-paar.com/en/amplitude-sweeps/ (accessed on 19 January 2023).
- Baby, D.K. Chapter 9. Rheology of hydrogels In Micro and Nano Technologies in Rheology of Polymer Blends and Nanocomposites; Sabu, T., Sarathchandran, C., Chandran, N., Eds.; Elsevier: Amsterdam, The Netherlands, 2020; pp. 193–204. [Google Scholar]
- Larson, R.G.; Wei, Y. A Review of Thixotropy and its Rheological Modeling. J. Rheol. 2019, 63, 477. [Google Scholar] [CrossRef]
- Mezger, T.G. Applied Rheology, 4th ed.; Anton Paar: Graz, Austria, 2017. [Google Scholar]
- Sánchez-Cid, P.; Jiménez-Rosado, M.; Alonso-González, M.; Romero, A.; Perez-Puyana, V. Applied Rheology as Tool for the Assessment of Chitosan Hydrogels for Regenerative Medicine. Polymers 2021, 13, 2189. [Google Scholar] [CrossRef] [PubMed]
- Kong, M.; Chen, X.G.; Xing, K.; Park, H.J. Antimicrobial properties of chitosan and mode of action: A state of the art review. Int. J. Food Microbiol. 2010, 144, 51–63. [Google Scholar] [CrossRef] [PubMed]
- Ceramella, J.; Iacopetta, D.; Catalano, A.; Cirillo, F.; Lappano, R.; Sinicropi, M.S. A Review on the Antimicrobial Activity of Schiff Bases: Data Collection and Recent Studies. Antibiotics 2022, 11, 191. [Google Scholar] [CrossRef] [PubMed]
- Goy, R.C.; Morais, S.; Assis, O. Evaluation of the antimicrobial activity of chitosan and its quaternized derivative on E. coli and S. aureus growth. Rev. Bras. Farmacogn. 2016, 26, 122–127. [Google Scholar] [CrossRef]

| No. | Sample | Polymer, % (w/w) | Ratio CS:oxCS | No. | Sample | Polymer, % (w/w) | Ratio CS:oxHA | ||
|---|---|---|---|---|---|---|---|---|---|
| CS | oxCS | CS | oxHA | ||||||
| 1 | CS1.0-oxCS2.0 | 1.0 | 2.0 | 1:2 | 4 | CS1.0-oxHA2.0 | 1.0 | 2.0 | 1:2 |
| 2 | CS1.5-oxCS1.5 | 1.5 | 1.5 | 1:1 | 5 | CS1.5-oxHA1.5 | 1.5 | 1.5 | 1:1 |
| 3 | CS2.0-oxCS1.0 | 2.0 | 1.0 | 2:1 | 6 | CS2.0-oxHA1.0 | 2.0 | 1.0 | 2:1 |
| No. | Sample | API % (w/w) | CS Hydrogels |
|---|---|---|---|
| 1 | FA-CS-oxCS | FA, 2.0% | CS1.5-oxCS1.5 |
| 2 | Ala-CS-oxCS | Ala, 1.0% | CS1.5-oxCS1.5 |
| 3 | CoQ10-CS-oxCS | CoQ10, 1.0% | CS1.5-oxCS1.5 |
| 4 | FA-CS-oxHA | FA, 2.0% | CS1.0-oxHA2.0 |
| 5 | Ala-CS-oxHA | Ala, 1.0% | CS1.0-oxHA2.0 |
| 6 | CoQ10-CS-oxHA | CoQ10, 1.0% | CS1.0-oxHA2.0 |
| No. | Parameter | Test Settings |
|---|---|---|
| 1 | amplitude (ɣ), % | 1–500 |
| 2 | angular frequency (ω), Hz | 1.6 |
| 3 | shear strain | oscillating |
| 4 | data points collected | 100 |
| No. | Parameter | Stage I (Rest Conditions) | Stage II (Deformation) | Stage III (Recovery) |
|---|---|---|---|---|
| 1 | amplitude, ɣ % | 0.1 | 700 | 0.1 |
| 2 | angular frequency (ω), Hz | 1.6 | 1.6 | 1.6 |
| 3 | data points collected | 30 | 30 | 30 |
| 4 | shear strain | oscillating | oscillating | oscillating |
| 5 | test time, s | 330 | 330 | 330 |
| No. | Sample | pH | No. | Sample | pH |
|---|---|---|---|---|---|
| 1 | CS1.0-oxCS2.0 | 5.952 | 7 | FA-CS-oxCS | 5.848 |
| 2 | CS1.5-oxCS1.5 | 6.012 | 8 | Ala-CS-oxCS | 5.893 |
| 3 | CS2.0-oxCS1.0 | 5.851 | 9 | CoQ10-CS-oxCS | 5.817 |
| 4 | CS1.0-oxHA2.0 | 5.820 | 10 | FA-CS-oxHA | 5.966 |
| 5 | CS1.5-oxHA1.5 | 5.770 | 11 | Ala-CS-oxHA | 5.939 |
| 6 | CS2.0-oxHA1.0 | 5.805 | 12 | CoQ10-CS-oxHA | 5.968 |
| No. | Sample | G′ (Pa) | G″ (Pa) | LVE, ɣ (%) | Yield Point, τ (Pa) |
|---|---|---|---|---|---|
| 1 | CS1.0-oxCS2.0 | 0.206 | 1.629 | 102 | 0.014 |
| 2 | CS1.5-oxCS1.5 | 4.733 | 6.600 | 101 | 0.002 |
| 3 | CS2.0-oxCS1.0 | 3.238 | 7.086 | 105 | 0.002 |
| 4 | CS1.0-oxHA2.0 | 507.380 | 16.845 | 83 | 311.010 |
| 5 | CS1.5-oxHA1.5 | 1199.400 | 20.321 | 77 | 452.440 |
| 6 | CS2.0-oxHA1.0 | 100.500 | 24.590 | 96 | 353.780 |
| 7 | FA-CS-oxCS | 0.418 | 2.334 | 100 | 0.015 |
| 8 | Ala-CS-oxCS | 1.295 | 2.707 | 98 | 0.003 |
| 9 | CoQ10-CS-oxCS | 0.423 | 2.673 | 99 | 0.001 |
| 10 | FA-CS-oxHA | 101.810 | 42.335 | 90 | 23.160 |
| 11 | Ala-CS-oxHA | 132.860 | 39.431 | 89 | 67.511 |
| 12 | CoQ10-CS-oxHA | 120.370 | 34.405 | 88 | 36.818 |
| No. | Sample | Loss Factor (tan δ) | Recovery, % | ||
|---|---|---|---|---|---|
| First Stage (Rest Condition) | Second Stage (Deformation) | Third Stage (Recovery) | |||
| 1 | CS1.0-oxCS2.0 | 0.129 | 36.800 | 0.134 | 95.338 |
| 2 | CS1.5-oxCS1.5 | 0.163 | 16.900 | 0.171 | 99.510 |
| 3 | CS2.0-oxCS1.0 | 0.541 | 5.165 | 0.547 | 99.765 |
| 4 | CS1.0-oxHA2.0 | 0.042 | 1.440 | 0.044 | 99.618 |
| 5 | CS1.5-oxHA1.5 | 0.170 | 2.180 | 0.031 | 36.456 |
| 6 | CS2.0-oxHA1.0 | 0.043 | 0.355 | 0.231 | 13.691 |
| 7 | FA-CS-oxCS | 0.422 | 28.900 | 1.030 | 73.087 |
| 8 | Ala-CS-oxCS | 0.410 | 25.200 | 2.730 | 70.556 |
| 9 | CoQ10-CS-oxCS | 0.854 | 53.900 | 0.918 | 70.943 |
| 10 | FA-CS-oxHA | 0.272 | 0.462 | 0.326 | 81.755 |
| 11 | Ala-CS-oxHA | 0.130 | 0.620 | 0.157 | 72.306 |
| 12 | CoQ10-CS-oxHA | 0.147 | 5.541 | 0.192 | 69.436 |
Disclaimer/Publisher’s Note: The statements, opinions and data contained in all publications are solely those of the individual author(s) and contributor(s) and not of MDPI and/or the editor(s). MDPI and/or the editor(s) disclaim responsibility for any injury to people or property resulting from any ideas, methods, instructions or products referred to in the content. |
© 2023 by the authors. Licensee MDPI, Basel, Switzerland. This article is an open access article distributed under the terms and conditions of the Creative Commons Attribution (CC BY) license (https://creativecommons.org/licenses/by/4.0/).
Share and Cite
Tatarusanu, S.-M.; Sava, A.; Profire, B.-S.; Pinteala, T.; Jitareanu, A.; Iacob, A.-T.; Lupascu, F.; Simionescu, N.; Rosca, I.; Profire, L. New Smart Bioactive and Biomimetic Chitosan-Based Hydrogels for Wounds Care Management. Pharmaceutics 2023, 15, 975. https://doi.org/10.3390/pharmaceutics15030975
Tatarusanu S-M, Sava A, Profire B-S, Pinteala T, Jitareanu A, Iacob A-T, Lupascu F, Simionescu N, Rosca I, Profire L. New Smart Bioactive and Biomimetic Chitosan-Based Hydrogels for Wounds Care Management. Pharmaceutics. 2023; 15(3):975. https://doi.org/10.3390/pharmaceutics15030975
Chicago/Turabian StyleTatarusanu, Simona-Maria, Alexandru Sava, Bianca-Stefania Profire, Tudor Pinteala, Alexandra Jitareanu, Andreea-Teodora Iacob, Florentina Lupascu, Natalia Simionescu, Irina Rosca, and Lenuta Profire. 2023. "New Smart Bioactive and Biomimetic Chitosan-Based Hydrogels for Wounds Care Management" Pharmaceutics 15, no. 3: 975. https://doi.org/10.3390/pharmaceutics15030975
APA StyleTatarusanu, S.-M., Sava, A., Profire, B.-S., Pinteala, T., Jitareanu, A., Iacob, A.-T., Lupascu, F., Simionescu, N., Rosca, I., & Profire, L. (2023). New Smart Bioactive and Biomimetic Chitosan-Based Hydrogels for Wounds Care Management. Pharmaceutics, 15(3), 975. https://doi.org/10.3390/pharmaceutics15030975

